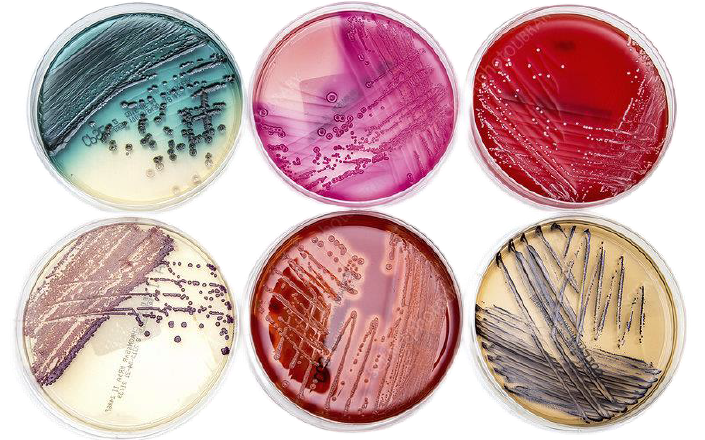

点击蓝字 关注《纺织导报》

在纺织印染行业,绿色发展成为大势所趋,行业绿色转型势在必行,这就促使工艺设计必须使用环保型化学品,而生物基纺织化学品正好能够契合当下需求,成为人们关注的重点。生物基纺织化学品主要包括生物基着色剂、生物基表面活性剂、生物基整理剂、纺织印染用酶助剂四大类。
01
生物基着色剂
生物基着色剂主要包括各种天然染料和色素,如栀子黄、姜黄、番茄红等植物源天然染料;胭脂虫红、贝紫等动物源色素;以及红曲色素等各种微生物色素。目前,Beta-胡萝卜素(三孢布拉霉菌等)、虾青素(雨生雨生红球藻等)也已实现规模化生产。
在前沿研究方面,有学者采用代谢工程手段进行微生物色素菌种的构建和代谢途径的调控,通过在大肠杆菌(非产色素菌)中导入微生物色素合成酶基因来改变代谢途径,获得了七彩色素。

02
生物基表面活性剂
生物基表面活性剂具有结构、性能多样化,环境相容性好等特性,常见的生物基表面活性剂包括糖脂、天然糖苷、合成烷基糖苷以及蛋白基表面活性剂、氨基酸基表面活性剂等。但在行业实际应用中,还存在价格高昂、规模化生产困难等瓶颈。

03
生物基整理剂
生物基整理剂的种类和功能也是多样化的,包括生物基无氟防水整理剂、壳聚糖抗菌整理剂、植酸阻燃剂等。其中,随着市场对防水功能性面料的需求量增加,以及相关政策法规对于含氟类化学品的管控越来越严格,生物基无氟防水整理剂成为行业热点。在4月份的第23届中国国际染料工业及有机颜料、纺织化学品展览会上,国内外企业如昂高、传化、德美、日华、中纺化工等纷纷推出了相关产品。

04
纺织印染用酶助剂
由于酶自身很容易被生物降解,且不需加入大量的化学品,能大大降低污水处理负担,所以纺织印染用酶助剂也是一类环保型生物基助剂。纺织印染用酶助剂在印染加工中的使用范围日益扩大,且随着技术的进步,新型酶制剂也在不断推出,其具有更高的效率、更广泛的适用性和更少的环境污染。

【回顾】往期精品微信:

欢迎转载,请标明出处,谢谢!
《纺织导报》杂志是中国纺织信息中心主办的导向性科技期刊,旨在对纺织技术发展动态进行深度的报道和分析,对科技政策和产业规则进行权威的解读,是政府机构、行业组织科技政策与思路趋向的风向标,是帮助行业与企业决策者把握纺织技术现状以及技术市场脉络的重要窗口。
纺织导报官方网站:www.texleader.com.cn
发行热线:010-84463638-8850
广告垂询:010-84463638-8830








